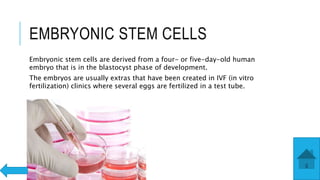
EMBRYONIC STEM CELLS
Embryonic stem cells are derived from a four- or five-day-old human
embryo that is in the blastocyst phase of development.
The embryos are usually extras that have been created in IVF (in vitro
fertilization) clinics where several eggs are fertilized in a test tube.

This document discusses stem cells, including what they are, their types and uses in medicine. It defines stem cells as undifferentiated cells that can differentiate into specialized cells. There are two main types of stem cells: embryonic stem cells derived from embryos, and adult stem cells found in adult tissues. Embryonic stem cells are the most versatile but also raise ethical issues, while adult stem cells are more limited but do not have ethical concerns. The document also notes how stem cell therapy uses stem cells to treat diseases by replacing damaged cells.